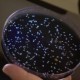
Castro: No Parece Apurarle a Rauner el Brote de los Legionarios

Yearly Archives: 2018
Chicago Park District Looking for Ambassadors
Meet visitors from around the world, while guiding them around two of the city’s most unique architectural and natural landscapes as a volunteer for the Lincoln Park Conservancy Docent program…. Read more
Illinois EPA Announces Draft Plan to Fund Alternate Fuel, Electric Projects
The state is unveiling its plan to spend its share of a multi-billion dollar Volkswagen Settlement. Illinois has been allocated more than $108 million dollars after it was discovered Volkswagen… Read more
Early Voting for Gubernatorial Primary Begins
Early voting for the March 20 Gubernatorial Primary Election began on Monday, with Cook County Clerk David Orr and the Chicago Board of Election Commissioners kicking it off with an… Read more
Berwyn Police Department to Conduct Special Patrols
The Berwyn Police Department announced it will conduct special patrols this St. Patrick’s Day to crack down on drunk drivers and encourage people to wear their seat belts. Widely celebrated… Read more
AT&T Bringing Custom Deals to Chicago
Beginning this week, AT&T is taking to the streets of the three largest U.S. cities—New York City, Chicago and Los Angeles with special limited time offers. “This is about giving… Read more
Bacteria de la Piel Beneficiosa Protege Contra el Cáncer de Piel
La ciencia continua quitando capas de piel microbiama para revelar sus propiedades protectoras. En un estudio publicado en Sciences Advances el 28 de febrero, investigadores de la Escuela de Medicina… Read more
Castro: No Parece Apurarle a Rauner el Brote de los Legionarios
La Senadora Estatal Cristina Castro (D-Elgin) continua buscando respuestas sobre la enfermedad epidémica de los Legionarios en Illinois Veterans Home en Quincy. El Comité de Asuntos del Veterano, de la… Read more
Sostenerse de las Manos Puede Sincronizar las Ondas Cerebrales
Sostenga la mano a un ser querido que sufre y no solo sincronizará su respiración y ritmo cardiaco con el de él, sino que las ondas cerebrales se acoplarán también,… Read more
Simpatizantes se Fijan la Meta de Graduar 90 Por Ciento de Estudiantes Desamparados para el 2030
SchoolHouse Connection, El Instituto para Niños, Pobres y Desamparados (ICPH), Empresas Cívicas y America’s Promise Alliance lanzaron Education Leads Home, primera campaña nacional de su clase enfocada exclusivamente en atender… Read more

Peruvian President Up for Impeachment?!
By: Daniel Nardini The Peruvian Congress may try to carry a second motion of impeachment on scandal-plagued Peruvian President Pedro Pablo Kuczynski. The first motion of impeachment, which failed, was… Read more »